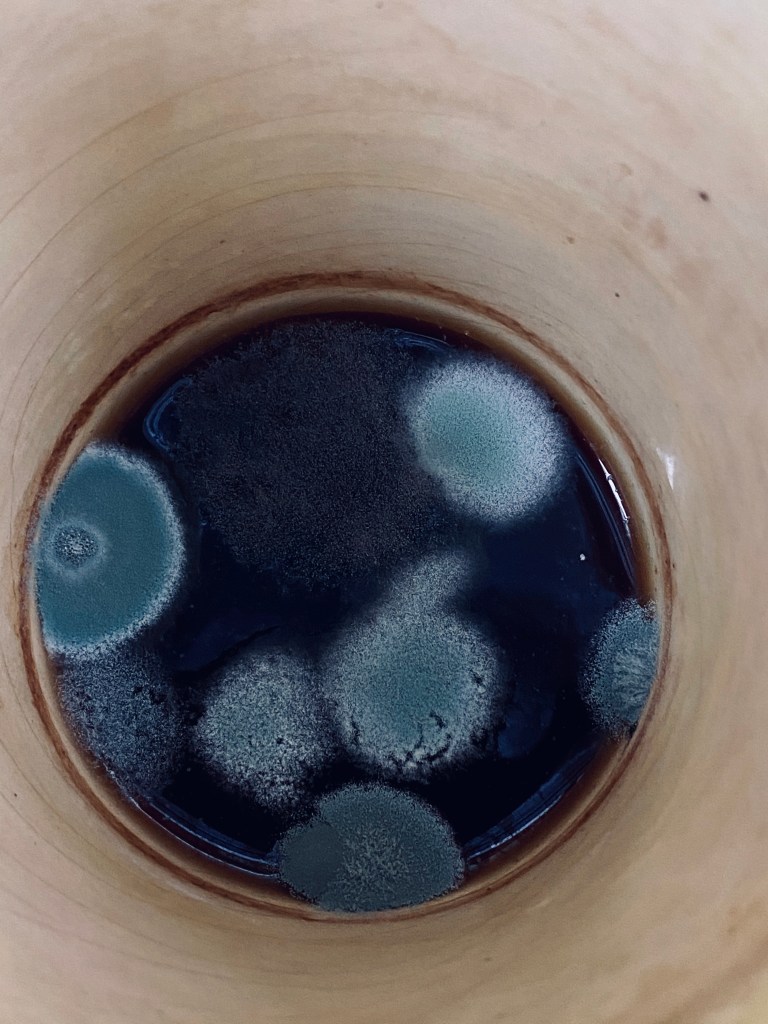

Experiments in the darkroom.

I’ve been working with colour for much of 2020, but I finally managed to spend an afternoon isolated in the darkroom before lockdown. I couldn’t take my mind of the pandemic, I found a cup of mouldy coffee lying around, and got inspired to show some contagion on my prints.
This test shows one of my mermaids immersed in contamination. It could be the beginning on a new project on the theme of Contagion – Contamination.